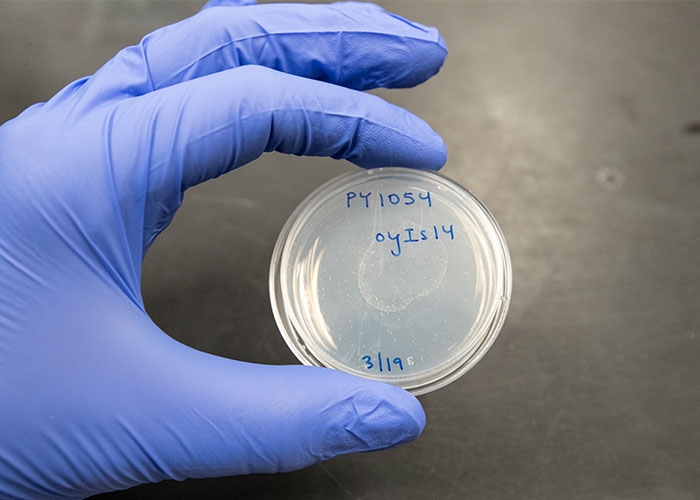
Alison Philbrook Lab
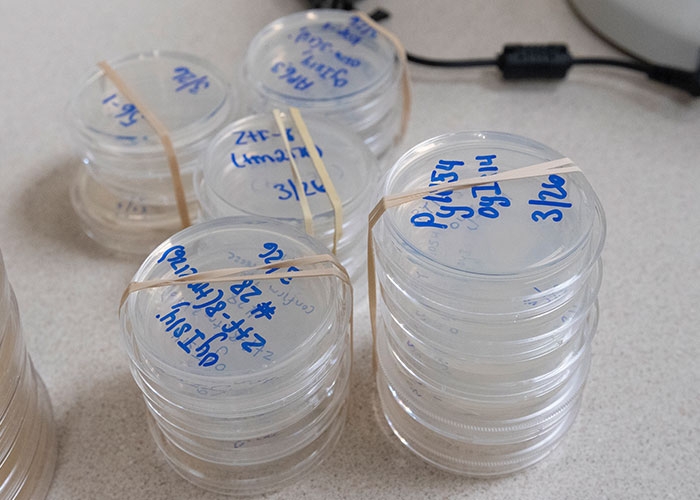
Alison Philbrook Lab

“There’s a reason why multiple Nobel-prize-winning biologists are worm biologists,” says Asst. Prof. Alison Philbrook. “A lot of what we learn from the worm is directly applicable to higher organisms.”
A worm is more like a human than you think. Despite obvious physical differences, many of the genes in the worm have counterparts in humans, which is why they’re often used as “model organisms” to study complex human diseases. In fact, according to RIC Assistant Professor of Biotechnology Alison Philbrook, worms may give us a clue about the human loss of smell.
Her research focuses on olfactory neurons, which are responsible for our sense of smell. Olfactory neurons extend cilia that look like tiny hairs into the nasal cavity of the human nose.
“It’s the cilia that does the heavy lifting,” she says. “Receptors within cilia bind to odorants in the environment. The olfactory neuron then sends a message to the brain, allowing the brain to determine if this smell is good or this smell is bad. Without cilia, we would have no sense of smell.”
“Because olfactory cilia are exposed to the environment, they are subject to injury and infection, resulting in a loss of smell,” says Philbrook, “however, these cilia can also regenerate.” She hopes to one day be able to identify the genes involved in cilia regeneration.
To that end, in her lab Philbrook is experimenting with the cilia found in the noses of C. elegans – a type of worm.
“C. elegans live in the soil and feed on the bacteria found in rotting fruit and vegetation. They’re not the size of earth worms. In fact they are only a millimeter long. Thousands of them can live on a single petri dish,” she says.

According to Philbrook, “C. elegans don’t have a vertebrate-style brain like humans but rather a cluster of neurons near the head of the worm. They also have a nose-like structure with cilia located at the tip of the nose. C. elegans rely heavily on their nose for survival. Without eyes, food sources are found primarily through their very good sense of smell.”
As a scientist, her overriding question is – If the cilia of the worm are damaged, how do the cilia regrow?
During her postdoctoral studies at Brandeis University, Philbrook first experimented with artificially truncating the cilia of C. elegans. She genetically engineered a mutant strain of C. elegans that if she placed them in an incubator and exposed them to a higher temperature it caused their cilia to truncate and that by shifting them back to a lower temperature it caused the cilia to regrow.
“I’m interested in what genes are involved in that regeneration,” she says. “If we can identify the gene or host of genes that are responsible for that regrowth, then we can look for equivalent genes in humans.”

Last summer, after examining thousands of worms, Philbrook sent out dozens of different strains of worms with defects in cilia regeneration to have their genomes sequenced.
“From those strains, we are trying to identify mutants that cause the cilia to fail to regrow. It’s a very nice starting place for my lab, because there are so many potential genes to explore,” she says.

In collaboration with the Sengupta Lab at Brandeis, three RIC undergrads are currently working in Philbrook’s lab: Joslin Guzman (biotechnology major), Ashley Lindo (biotechnology major) and Diana Jean-Louis (health sciences major). Both teams are intent on solving this biological mystery. Their first task is to separate the worms by their genetic makeup and examine their cilia. Because the worms are so tiny and there are so many of them, the students examine them through a high-powered microscope and use what is called a worm pick, which basically looks like a pen with a wire on the tip to pick up the worm, to place them into separate petri dishes.
She notes, “There’s a reason why multiple Nobel-prize-winning biologists are worm biologists. A lot of what we learn from the worm is directly applicable to higher organisms. I’m hoping that we can identify a host of genes involved in cilia regrowth and that they become potential avenues to begin looking at higher organisms.”
RIC students who have an interest in neurobiology, genetics, molecular biology and/or animal behavior are welcome to apply for undergraduate research with Philbrook.
To learn more about the research being done in RIC’s Department of Biology, visit Biology Research.
